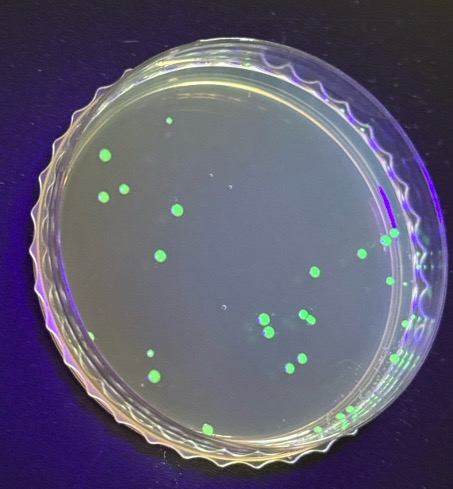

MINT News
Wir machen mehr MINT am Neufeld!

❤️
MINT-Modul III: Roboterprojekt mit Lego Mindstorms vom 12. Januar bis am 9. März 2026
In diesem Robotik-Modul konstruierten und programmierten die Schülerinnen und Schüler eigene autonome Lego-MINDSTORMS-Roboter. Die Herausforderung: Auf einer Fläche von einem Quadratmeter mussten die Roboter selbstständig Ballons aufspüren und mit einer Nadel zum Platzen bringen.
Mit grosser Begeisterung und technischer Kreativität entwickelten die Teams unterschiedlichste Strategien – von präzisen Stich-Techniken bis hin zu „brachialen“ Sense-Methoden. In einem packenden Wettbewerb traten die Konstruktionen schliesslich gegeneinander an. Das grosse Finale fand in einer vierfach vergrösserten Arena statt, wo die besten zwei Roboter im direkten Duell aufeinandertrafen. Dramatik pur: Durch einen unerwarteten Defekt am Favoriten-Fahrzeug lagen Sieg und Niederlage am Ende dicht beieinander.
Alle Beteiligten blicken auf ein spannendes Modul zurück und sind nun um wertvolle Erfahrungen in Robotik und Maschinenbau reicher.
Film: Kampf der Lego-Roboter
Bericht, 31. März 2026
Freifach MINT
MINT-Module I-IV im Schuljahr 2026/27
Im Schuljahr 2026/27 bietet die Abteilung MN vier neue spannende MINT-Module für die Stufen GYM2 und GYM3 an. Jedes dauert kompakt 7 Wochen. An der Abteilung MN läuft schon das zweite MINT-Jahr. Wir freuen uns sehr auf die MINT-Module 2.0.
Useless Machine with an Attitude
MINT-Modul I: KW 34–37 und 42–44 (15 MINT-Punkte)
Leitung: Lehrpersonen der Fachschaften Chemie, Informatik und Mathematik
Eine Useless-Machine macht genau etwas: Wenn man sie einschaltet, schaltet sie sich selbst wieder aus. Unsere Version zeigt zusätzlich Emotionen: Wenn sie wiederholt eingeschaltet wird, reagiert sie genervt, und zeigt dies auch. Die Schüler*innen «zeichnen» ihre eigene dreidimensionale Halterung für die Maschine, welche wir dann per 3D-Druck herstellen. Ein Mikrocontroller wird danach mit einem Schalter und Servomotor verlötet und die Maschine zusammengebaut. Schliesslich programmieren wir die Maschine. Zuerst in einer einfachen Version, später hauchen wir der Maschine Emotionen ein.
Molekularbiologische Methoden
MINT-Modul II: KW 45–51 (15 MINT-Punkte)
Leitung: Lehrpersonen der Fachschaften Biologie und Chemie
Molekularbiologische Methoden verstehen und anwenden: Von der DNA-Extraktion bis zum Protein. In diesem Modul arbeiten Sie vor allem praktisch im Labor und führen Schritt für Schritt molekularbiologische Methoden durch. Sie extrahieren DNA, setzt PCR an und kontrollieren Ergebnisse mit Gel-Elektrophorese. Anschliessend führen Sie Klonierung, Proteinexpression und Aufreinigung aus und überprüfen die Qualität Ihrer Produkte.
Lego-Roboterprojekt Nr. 2
MINT-Modul III: KW 2–4 und KW 7–10 (15 MINT-Punkte)
Leitung: Lehrpersonen der Fachschaft Physik
Interessieren Sie sich für den Beruf des Maschinenbauingenieurs? Oder könnten Sie sich vorstellen, etwas im Bereich Robotik zu studieren? In diesem Modul schnuppern Sie in diese Tätigkeitsfelder hinein, indem Sie in Zweierteams einen autonomen Lego MINDSTORMS-Roboter bauen und programmieren.
PS: Programmierkenntnisse sind nicht erforderlich – die verwendete grafische Programmiersprache LabVIEW ist sehr intuitiv.
PPS: Wer bereits das letztjährige Roboter-Projekt besucht hat, ist selbstverständlich auch diesmal herzlich willkommen – wir werden uns einer neuen spannenden Aufgabe zuwenden!
Botanischer Garten
MINT-Modul IV: KW 11–14 und 17–19 (15 MINT-Punkte)
Leitung: Lehrpersonen der Fachschaft Biologie
Sie erleben den Botanische Garten garantiert anders: 1. Mittelmeerhaus: Welche Lebensformen erwarten wir bei Pflanzen im Mittelmeerraum? Können Pflanzen des Mittelmeerklimas bei uns im Freien überleben? 2. Wo gibt es kontinentale Steppen weltweit und welche Pflanzen leben dort? Warum gibt es viele Frühblüher? 3. Gondwana, ein alter Superkontinent: Was ist heute davon erhalten? 4. Wie können wir Pflanzen über Stecklinge vermehren? 5. Wie kultiviert man Orchideen im Orchideenhaus? 6. Sie sehen die Evolution der Pflanzenwelt an lebenden Beispielen. 7. Sie erleben den Frühling im Alpinum des Botanischen Gartens in Bern. 8. Wir vergleichen Pflanzen der Kanarischen Inseln mit den Schwerpunkten Endemiten, Evolution und Höhenstufen.
Freifach MINT, 01.03.2026
MINT-Modul II: Die faszinierende Welt der Proteine vom 10. November 2025 bis 5. Januar 2026
Im MINT-Modul II vertieften sich die Schüler*innen in die Welt der Proteine. Dabei setzten sie sich sowohl theoretisch als auch praktisch mit dem Aufbau und der Funktion von Proteinen auseinander. Zu Beginn erhielten sie eine Übersicht über die verschiedenen Strukturebenen von Proteinen – von der Primärstruktur über Sekundär- und Tertiärstruktur bis hin zur Quartärstruktur – sowie über die Bedeutung der Proteinfaltung für die biologische Funktion.
Zur Veranschaulichung der Proteinstrukturen erstellten die Schüler*innen Papiermodelle typischer Sekundärstrukturelemente wie α-Helices und β-Faltblätter. Darüber hinaus wurde die Tertiärstruktur exemplarisch am Green Fluorescent Protein (GFP) erarbeitet, wobei dessen Struktur, Funktion und Bedeutung als Reportergen thematisiert wurden. Ergänzend zu den analogen Modellen arbeiteten die Schülerinnen computergestützt mit dem Programm PyMOL, um Proteinstrukturen dreidimensional darzustellen und zu analysieren.



Zusätzlich erhielten die Schüler*innen eine Anschauung zu genetisch transformierten E.-coli-Zellen, die GFP exprimieren. Dabei wurden fluoreszierende Bakterienkolonien auf Agarplatten unter UV-Licht betrachtet. Das grüne Leuchten der GFP-exprimierenden Transformanten diente als anschauliches Beispiel für die erfolgreiche Expression eines Reportergens.
Anschliessend wurde eine GFP-Aufreinigung mittels Ni-NTA-Affinitätschromatographie vorgestellt. Das His-getaggte GFP bindet dabei spezifisch an die Ni-NTA-Matrix und konnte während der Elution anhand seiner grünen Fluoreszenz unter UV-Licht sichtbar gemacht werden.
Ergänzend dazu erhielten die Schüler*innen mit dem Computerspiel Foldit einen ersten Einblick in die Proteinfaltung. In diesem wissenschaftsbasierten Spiel verändern und optimieren sie Proteinstrukturen, um grundlegende Zusammenhänge zwischen Faltung, Stabilität und Funktion zu verstehen.

Kurzbericht, 06.02.2026
MINT-Modul I: MINTeresting Evenings – MINT-Modul I vom 18. August bis 3. November 2025
An den MINTeresting Evenings sind die MINT-interessierten Schüler*Innen in die Welt der Chemie, Biologie und Geografie eingetaucht und haben Einblicke in die praktische MINT-Arbeit erhalten.
Im Chemielabor haben die Schüler*innen ihr eigenes Papier geschöpft, die Seiten als Vorbereitung für das Binden gelocht, diese nach Anleitung geheftet, sie mit verschiedenfarbigem Garn zu ihrem Notizheft zusammengebunden und die Heftseite nach einem Rezept für selbstgemachte Eisengallustinte beschriftet und gestaltet.












Darin haben sie ihre spannenden Entdeckungen notiert: die Erkenntnisse der angeleiteten Hühnerschenkel-Sektion im Biologielabor sowie die Notizen bei der der Taubenzählung in der Stadt Bern.






Mit Lehrpersonen der Fachschaft Geografie haben sie in Zusammenarbeit mit Stefan Brönimann, Janine Wintzer und Moritz Gubler vom Geografischen Institut der Universität Bern (GIUB) und der PH Bern haben sie ein nachhaltiges Stadtquartier erkundet: das UrbanLab Viererfeld der Stadt Bern.


Am Ende des Moduls haben sie ein Forschungsheft mit den selbst notierten Beobachtungen und gesammelten Proben und Eindrücken in den Händen gehalten.






Beim Abschluss-Apéro des MINT-Moduls I mit dem Titel MINTeresting Evenings haben die Schüler*innen einen MINT-Stempel in ihrem Testatheft erhalten.
Kurzbericht, 03.11.2025
MINT-Austausch Sek I – Sek II vom 5. September 2025
Beim MINT-Austausch Sek I – Sek II am 5. September 2025 konnten 80 Sek I-Schüler*innen des Hochfelds 1 MINT-Anwendungen erleben, sei es im Biologie- oder Chemielabor, mit dem Drumcomputer, mit dem Teleskop auf dem Dach oder bei Experimenten mit Licht im Schulzimmer. Wir danken allen beteiligten MINT-Lehrpersonen herzlich für ihr MINT-Engagement und die tollen Experimente!
Die Sek I-Schüler*innen waren fasziniert. Der Peer-Austausch mit den helfenden Gymnasiast*innen hat sie so gepackt, dass einige darüber die Z’Vieri-Pause vergessen haben. Viele verabschiedeten sich mit glänzenden Augen von ihren Lehrpersonen und der Abteilungsleitung MN. Wir freuen uns darauf, im nächsten Jahr einen weiteren MINT-Austausch Sek I – Sek II mit den 8. Klassen des Hochfelds 1 zu planen.











Kurzbericht, 18.09.2025
Mobiler Makerspace
Aus der Raumnot machen wir eine Tugend: Das Gymnasium Neufeld hat zum Schuljahr 2025/26 einen mobilen Makerspace geschaffen. Die beiden Werkbänke aus massiver Buche sind auf Rollen. Maker*innen können sie in Begleitung ihrer Lehrperson(en) vor Ort im Raum 2.28 nutzen oder an einen anderen Ort bzw. in einen anderen reservierten Raum fahren. Auf den Werkbänken ist alles Material für Handwerks- und Elektronikarbeiten installiert – zum Bohren, Dekupieren, Feilen, Löten, Sägen, Schleifen und Schrauben. Ausserdem arbeiten unsere vier 3D-Drucker regelmässig, zwei in der Fachschaft Chemie und zwei in der Fachschaft Physik; einer läuft (oft) im Physik-Schaufester im zweiten Stock des Südgebäudes.
Am Dienstag, dem 2. September 2025, hat das Kick-off für den mobilen Makerspace stattgefunden. Die beteiligten MINT-Fachschaften und die Abteilungsleitung MN wünschen allen Maker*innen viel Spass und tolle Erfahrungen.






Ankündigung, 02.09.2025
MINT-Austausch Sek I – Sek II, Schuljahr 2025/26, 5. September 2025, 14:15–17:00 Uhr
Wir vom Gymnasium Neufeld freuen uns sehr auf den kompakt an einem Herbstnachmittag stattfindenden MINT-Austausch (Sek I – Sek II). Beim stufenübergreifenden MINT-Austausch Sek I – Sek II am 5. September 2025 bieten die MINT-Fachschaften der Abteilung MN des Gymnasiums Neufeld den rund 80 Schüler*innen der 4 angemeldeten Klassen zwei Serien mit jeweils 6 Modulen à 45 Minuten an: Jede*r Schüler*in belegt zwei verschiedene Module, die er oder sie priorisiert hat. Die Schüler*innen finden sich in interessenbezogenen Gruppen zusammen und arbeiten mit einer praxisorientierten Forschungshaltung.
Bei fast allen Modulen werden Gymer-Schüler*innen (GYM3 und GYM4) die Lehrpersonen unterstützen und die Sek I–Schüler*innen während der Experimente anleiten helfen. Der Peer-to-Peer-Austausch wird so auf beiden Stufen gefördert.
MINT- Module zur Auswahl:
- Pilze untersuchen, Gewebeschnitte erstellen und mikroskopieren (Stephan Epple, Biologie)
- „Funken, Farben, Forschen!“ – Spitzerbatterie, Flammenfärbung, Knallgaselektrolyse (Fachschaft Chemie)
- Drumcomputer in JavaScript (Fachschaften Anwendungen der Mathematik und Informatik)
- Mit dem Teleskop den Himmel betrachten (Fachschaften Astronomie bzw. Physik)
- Pflanzenvermehrung, Fotosynthese, Mikroskopieren (Fachschaft Biologie)
- Dem Erbgut auf der Spur: DNA sichtbar machen und verstehen – Praktischer Teil I: DNA aus Früchten isolieren, Praktischer Teil II: DNA «basteln» (Fachschaften Biologie und Chemie)
Der Ablauf des MINT-Austauschs sieht wie folgt aus: Nach dem Empfang um 14:15 Uhr in der Grossen Halle begleiten die Gymer-Schüler*innen die Modulgruppen zu ihren jeweiligen Räumen. Das 1. MINT-Modul dauert von 14:40–15:25 Uhr. Danach ist Pause mit einem Z’Vieri in der Grossen Halle, damit die Sek I-Schüler*innen gestärkt in das 2. MINT-Modul von 16:00–16:45 Uhr gehen. Danach verabschiedet die Abteilungsleitung MN die Hochfeld-Schüler*innen.
Information, 01.09.2025
MINT-Austausch Sek I – Sek II, Schuljahr 2025/26
Am 5. September 2025 findet der MINT-Austausch kompakt an einem Nachmittag mit vier Klassen der Sek I-Schule Hochfeld 1 statt. Wir freuen uns schon jetzt sehr auf die Begegnungen und den stufenübergreifenden Austausch! Informationen folgen.
Ankündigung, 08.08.2025
Freifach MINT
MINT-Module I-IV im Schuljahr 2025/26
MINT-interessierte Schüler*innen der Abteilung MN (GYM2 und GYM3) belegen eines, mehrere oder alle Module des Freifachs MINT (montags, 2 Lektionen, 17:20–19:00 Uhr). Die vier aufeinanderfolgenden fächerübergreifenden, interdisziplinären und projektartigen MINT-Module (I-IV) dauern jedes kompakt sieben Wochen. Die Schüler*innen widmen sich in interessenbezogenen Gruppen spezifischen MINT-Fragen und arbeiten mit einer praxisorientierten Forschungshaltung.
MINTeresting Evenings
MINT-Modul I: KW 34–36 und 42–45 (15 MINT-Punkte)
Leitung: Lehrpersonen der Fachschaften Biologie, Chemie und Geografie
In diesem Modul tauchen Sie in die Welt der Chemie, Biologie und Geografie ein und erhalten Einblicke in die praktische MINT-Arbeit. Sie schöpfen Ihr eigenes Papier, binden ein Notizheft und stellen Tinte her.
Ihr Notizheft füllen Sie dann mit spannenden Entdeckungen: Von einer Taubenzählung in der Stadt, einer Hühnerschenkel-Sektion bis hin zur Erkundung eines nachhaltigen Stadtquartiers. Sie notieren Beobachtungen und sammeln Proben und Eindrücke. Am Ende halten Sie Ihr Forschungsheft in den Händen – gefüllt mit Wissen und Erlebnissen!
Die faszinierende Welt der Proteine
MINT-Modul II: KW 46–51 und KW 2 (15 MINT-Punkte)
Leitung: Lehrpersonen der Fachschaften Biologie und Chemie
Tauchen Sie ein in die Welt der Proteine – interaktiv mit VR-Brille und Resin-3D-Drucker! Erforschen Sie komplexe Proteinstrukturen und verstehen Sie, wie ihre dreidimensionale Form ihre Funktion bestimmt. Voraussetzung sind solide Kenntnisse über Atombindungen und zwischenmolekulare Kräfte. Erleben Sie Proteine virtuell und als gedrucktes Modell und erweitern Sie Ihr Fachwissen, um biologische Prozesse auf molekularer Ebene besser zu verstehen.
Roboterprojekt mit Lego Mindstorms
MINT-Modul III: KW 3–4 und KW 7–11 (15 MINT-Punkte)
Leitung: Lehrpersonen der Fachschaft Physik
Interessieren Sie sich für den Beruf des Maschinenbauingenieurs? Oder könnten Sie sich vorstellen, etwas im Bereich Robotik zu studieren? In diesem Modul können Sie in diese Tätigkeitsfelder hineinschnuppern, indem Sie in Zweierteams einen autonomen Lego MINDSTORMS-Roboter bauen und programmieren.
PS: Programmierkenntnisse sind nicht erforderlich – die verwendete grafische Programmiersprache LabVIEW ist sehr intuitiv.
Biologische Exkursionen am Abend
MINT-Modul IV: KW 12–14 und 17–20 (15 MINT-Punkte)
Leitung: Lehrpersonen der Fachschaft Biologie
Auf der ersten Abendexkursion erkunden wir den Buchenwald auf der Halbinsel Reichenbach. Bei der zweiten Exkursion bewundern wir wildwachsende Orchideen und entdecken die botanisch kostbaren Trockenrasen entlang des Wohlensees. Auf zwei weiteren Exkursionen suchen und betrachten wir die wichtigsten Pilze, die im Bremgartenwald wachsen.
Freifach MINT, 20.03.2025
MINT-Austausch Sek I – Sek II, Schuljahr 2024/25
Im Rahmen der erneuten MINT-Zertifizierung (2024-2029) durch die Akademie der Naturwissenschaften fördern wir den stufenübergreifenden Austausch der Sekundarschule I und der Sekundarschule II.
Das Gymnasium Neufeld hat im ersten Semester 2024/25 mit der Sekundarschule Hochfeld 1 einen MINT-Austausch mit insgesamt vier Klassen durchgeführt mit dem Ziel, die Schüler*innen der Sekundarstufe I für die MINT-Fächer zu sensibilisieren. Wir freuen uns auf beiden Seiten sehr über diesen stufenübergreifenden Austausch.



Nach einem Znüni in der Mensa haben die Fachschaften Chemie und Biologie insgesamt vier Sek I-Klassen im Labor empfangen und mit ihnen Experimente durchgeführt:



Die Klasse 8g hat im Chemielabor eine Münze galvanisiert; die Klasse 8b hat eine Spitzerbatterie hergestellt und den Bunsenbrenner kennengelernt; die Klasse 8e hat ebenfalls eine Münze galvanisiert, eine Spitzerbatterie hergestellt und mit dem Bunsenbrenner gearbeitet; und die letzte Klasse 8d hat im Biologielabor Pflanzenstecklinge geschnitten und vermehrt, die Fotosynthese durchgenommen, Blattfarbstoffe isoliert, eine Papierchromatographie durchgeführt und einen Blattquerschnitt im Mikroskop betrachtet.



Kurzbericht, 06.12.2024